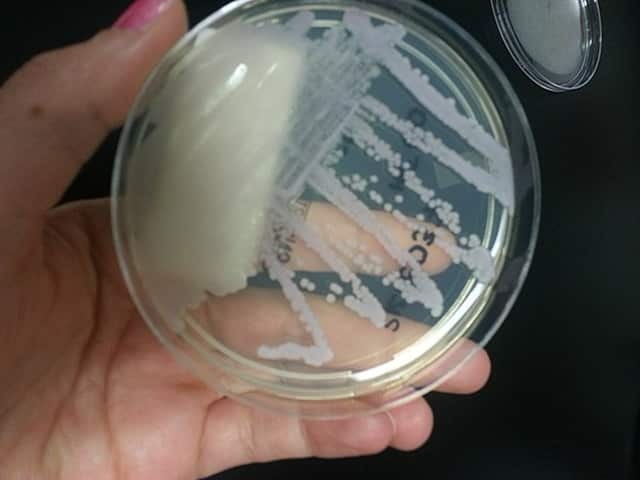
C. tropicalis in culture

Main menu
Common skin conditions
NEWS
Join DermNet PRO
Read more
Quick links
Authors: Riyad N.H. Seervai, MD/PhD student at Baylor College of Medicine, Houston, Texas, USA; Claire Jordan Wiggins, Medical Student at Baylor College of Medicine, Houston, Texas, USA. Reviewed by Dr Jane Morgan, Sexual Health Physician, Hamilton, New Zealand. DermNet Editor-in-Chief: Adjunct A/Prof. Amanda Oakley, Dermatologist, Hamilton, New Zealand. Copy edited by Gus Mitchell. February 2020.
Introduction
Demographics
Clinical features
Diagnosis
Treatment
Candida auris: an emerging species
Non-albicans candida infections are fungal infections caused by the Candida species of yeast other than C. albicans. These include:
The incidence of non-albicans candidiasis has been increasing over recent years.
Of the known non-albicans candida species, only C. tropicalis, C. parapsilosis, and C. orthopsilosis can be found on healthy skin (commensal microorganisms) and can become pathogenic [2].
Infections typically develop in the context of wounds or broken skin, pre-existing illness, or immunosuppression.
The clinical features and complications of non-albicans candidiasis are usually very similar or indistinguishable from candidiasis caused by C. albicans [3].
Vulvovaginal candidiasis is one of the most frequent infections experienced by adult women [4]. It presents with vulval irritation, itching, soreness, discomfort with sexual activity (dyspareunia), and a curdy-white vaginal discharge [4]. Many non-albicans species have been identified in vulvovaginal candidiasis, with most cases associated with C. glabrata, C. krusei, C. tropicalis, C. parapsilosis, and C. dubliniensis.
Candida species are a part of the normal oral flora of healthy individuals. Oral candidiasis is caused by an overgrowth of Candida species in the mouth. The two main forms are white oral candidiasis (pseudomembranous candidiasis, hyperplastic candidiasis) and erythematous oral candidiasis (atrophic candidiasis, median rhomboid glossitis, angular cheilitis, linear gingival erythema). Other forms are chronic mucocutaneous candidiasis, cheilocandidiasis (candida affecting lips), and chronic multifocal candidiasis [6].
Non-albicans species implicated in oral candidiasis include:
Systemic candidiasis is the invasion and growth of Candida in specific organ systems (also called disseminated candida) or the bloodstream (candidaemia). It is an opportunistic infection.
All candida infections are diagnosed by their typical clinical features and by seeing pseudohyphae and yeast forms on microscopy of swabs and scrapings. See laboratory test for fungal infections.

Microscopy of C. dubliniensis
C. tropicalis in culture
Candida infections are treated using the three approved classes of antifungals: azoles, echinocandins, and amphotericin B. Resistance to azoles, while rare in C. albicans, is frequent with non-albicans species [1,3].
The most common topical antifungal medications used in treatment trials for cutaneous candidiasis are clotrimazole, nystatin, and miconazole, and they show equivalent efficacy [11].
Boric acid intravaginal suppositories have been reported to achieve mycological cure for vulvovaginal candidiasis caused by C. glabrata, C. tropicalis, and C. lusitania. [12].
Systemic/oral antifungal medications for cutaneous candidiasis include fluconazole and itraconazole. Voriconazole and posaconazole are reserved for serious systemic candidiasis.
C. auris is a multidrug-resistant pathogen increasing in incidence since its initial isolation and recognition from an ear swab in 2009 [13]. Systemic candidiasis in critically ill patients on broad-spectrum antibiotics and/or antifungals has been the most common presentation. Skin and soft tissue infections including wound infections, have also been recognised [13].
Treatments for C. auris are extremely limited; echinocandins are the most frequently recommended option, though several strains are believed to be resistant to all antifungals. Off-patent or repurposed drugs are being investigated for the treatment of C. auris infections [15,16].